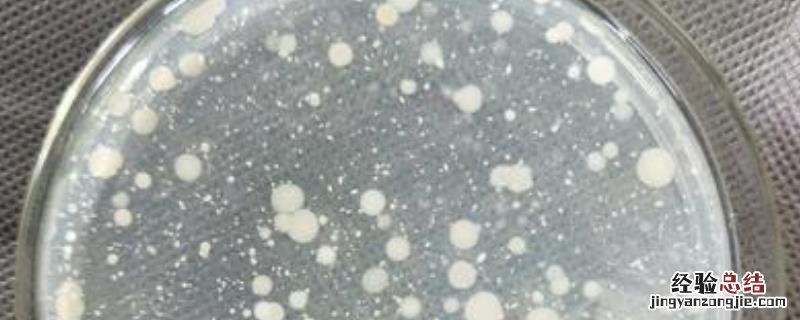

文章插图
回答膨化食品的菌落总数不得超过10000cfu/g,大肠菌群不得超过90MPN/100g 。固体饮料产品的菌落总数不得超过1000cfu/g,大肠菌群应不得超过90MPN/100g,霉菌不得超过50cfu/g 。食醋中的菌落总数不得超过10000cfu/mL 。
一、菌落总数标准
1、膨化食品:膨化食品的菌落总数不得超过10000cfu/g,大肠菌群不得超过90MPN/100g 。
2、固体饮料:固体饮料产品的菌落总数不得超过1000cfu/g,大肠菌群应不得超过90MPN/100g,霉菌不得超过50cfu/g 。
3、糕点、面包、月饼:月饼产品中菌落总数不得超过1500cfu/g,大肠菌群不得超过30MPN/100g,霉菌不得超过100cfu/g 。蛋糕产品中的菌落总数不得超过10000cfu/g,大肠菌群不得超过300MPN/100g,霉菌不得超过150cfu/g 。
4、食醋:食醋中的菌落总数不得超过10000cfu/mL。
5、饼干:非夹心饼干的菌落总数不得超过750cfu/g,夹心饼干的菌落总数不得超过2000cfu/g,饼干产品的霉菌计数不得超过50cfu/g 。
6、灭菌乳:灭菌乳菌落总数不得超过10cfu/g,大肠菌群不得超过3MPN/100g 。
7、冷冻饮品:含淀粉或果类的冷冻饮品菌落总数不得超过3000cfu/g , 大肠菌群不得超过100MPN/100g , 含乳蛋的冷冻饮品的菌落总数不得超过25000cfu/g,大肠菌群不得超过450MPN/100g 。
8、蜜饯:蜜饯食品中菌落总数不得超过1000cfu/g,霉菌不得超过50cfu/g 。
9、调味品:鸡精调味料中大肠菌群不得超过90MPN/100g 。
10、瓶装水:饮用纯净水的菌落总数不得超过20cfu/ml,大肠菌群不得超过3MPN/100ml 。瓶(桶)装饮用水的菌落总数不得超过50cfu/ml,大肠菌群不得超过3MPN/100ml 。天然矿泉水的菌落总数不得超过50cfu/ml,大肠菌群应为0 。
11、酱腌菜:酱腌菜产品的大肠菌群不得超过30MPN/100g 。
12、食糖:白砂糖、绵白糖的菌落总数不得超过100cfu/g 。
13、肉干、肉脯:肉制品中大肠菌群不得超过30MPN/100g 。
14、油炸小食品:油炸类炒货大肠菌群不得超过30MPN/100g 。
15、果、蔬汁饮料:果(蔬)汁及果(蔬)汁饮料产品的菌落总数不得超过100cfu/mL,酵母不得超过20cfu/mL 。
16、果冻:果冻中菌落总数不得超过100cfu/g , 大肠菌群不得超过30MPN/100g 。
17、黄酒:黄酒产品的菌落总数不得超过50cfu/ml 。
18、芝麻酱:芝麻酱产品的大肠菌群不得超过90个/100g 。
19、碳酸饮料:碳酸饮料产品的酵母不得超过10cfu/mL,菌落总数不得超过100cfu/mL,大肠菌群不得超过6MPN/100mL 。
20、熟肉制品:熟肉制品的菌落总数不得超过30000cfu/g 。
21、豆制品、面筋:定型包装非发酵豆制品的菌落总数不得超过750cfu/g;定型包装发酵性豆制品的大肠菌群不得超过30MPN/100g 。
22、方便面:方便面的面块+调料菌落总数不得超过50000cfu/g,大肠菌群不得超过150MPN/100g 。
【菌落总数标准,菌落总数计数方法 菌落总数标准要求】二、菌落总数计数方法
1、具体操作方法
(1)培养到一定时间后,计算每个平板上的菌落数 。可用肉眼观察,必要时可以使用放大镜检查 。记下各平板的菌落总数后,求出同稀释度的各平板平均菌落数 , 计算出原始样品中每克(或每毫升)中的菌落数 。
(2)到达规定培养时间后,应当立即计数 。如果不能立即计数,应将平板放置于0-4℃的环境下,且不得超过24小时 。
2、菌落数选择
(1)当平板上面有链状菌落生长,如果呈链状生长的菌落之间没有任何明显界限 , 则应作为一个菌落计算;如存在有几条不同来源的链,则每条链均应按一个菌落计算,不能把链上生长的每一个菌落分开计数 。
(2)当平板上面有片状菌落生长,该平板一般不宜采用,如果片状菌落不到平板的一半 , 而另一半又分布均匀,则可以使用半个平板的菌落数乘以2代表全平板的菌落数 。
(3)当平板内的菌落数过多(即所有稀释度均大于300时),但分布很均匀的时候,可取平板的一半或四分之一计数,再乘以相应稀释倍数作为该平板的菌落数 。
(4)不同稀释度的菌落数应与稀释倍数成反比(同一稀释度的二个平板的菌落数应基本接近),即稀释倍数愈高菌落数愈少 , 稀释倍数愈低菌落数愈多 。如果出现逆反现象,应视为检验中的差错,不作为检样计数报告的依据 。
3、稀释度选择
(1)计数时应选取菌落数在30-300之间 , 无蔓延菌落生长的平板(SN标准要求为25-250个菌落),然后乘以稀释倍数进行报告 。
(2)如果稀释度均大于300,则取最高稀释度的平均菌落数乘以稀释倍数报告 。
(3)如果稀释度均小于30,则以最低稀释度的平均菌落数乘稀释倍数报告 。
(4)如果菌落数有的大于300,有的又小于30,但均不在30-300之间,则应以最接近300或30的平均菌落数乘以稀释倍数报告 。
(5)如果所有稀释度均无菌落生长,则应按小于1乘以最低稀释倍数报告 。
(6)如果2个稀释度均在30-300之间,按国家标准方法要求应以二者比值决定,比值小于或等于2时取平均数,比值大于2则选择较小数字 。
(7)如果只有一个稀释度平板上的菌落数在30-300之间,应当计算两个平板菌落数的平均值,然后根据平均值乘以相应稀释倍数进行计算 。
4、报告
(1)当菌落数在1-100以内时,按照实际数字进行报告 。如果菌落数大于100时 , 报告前2位有效数字,第3位数四舍五入计算 。
(2)固体检样以克为单位报告,液体检样以毫升为单位报告,表面涂擦则以平方厘米为单位报告 。
